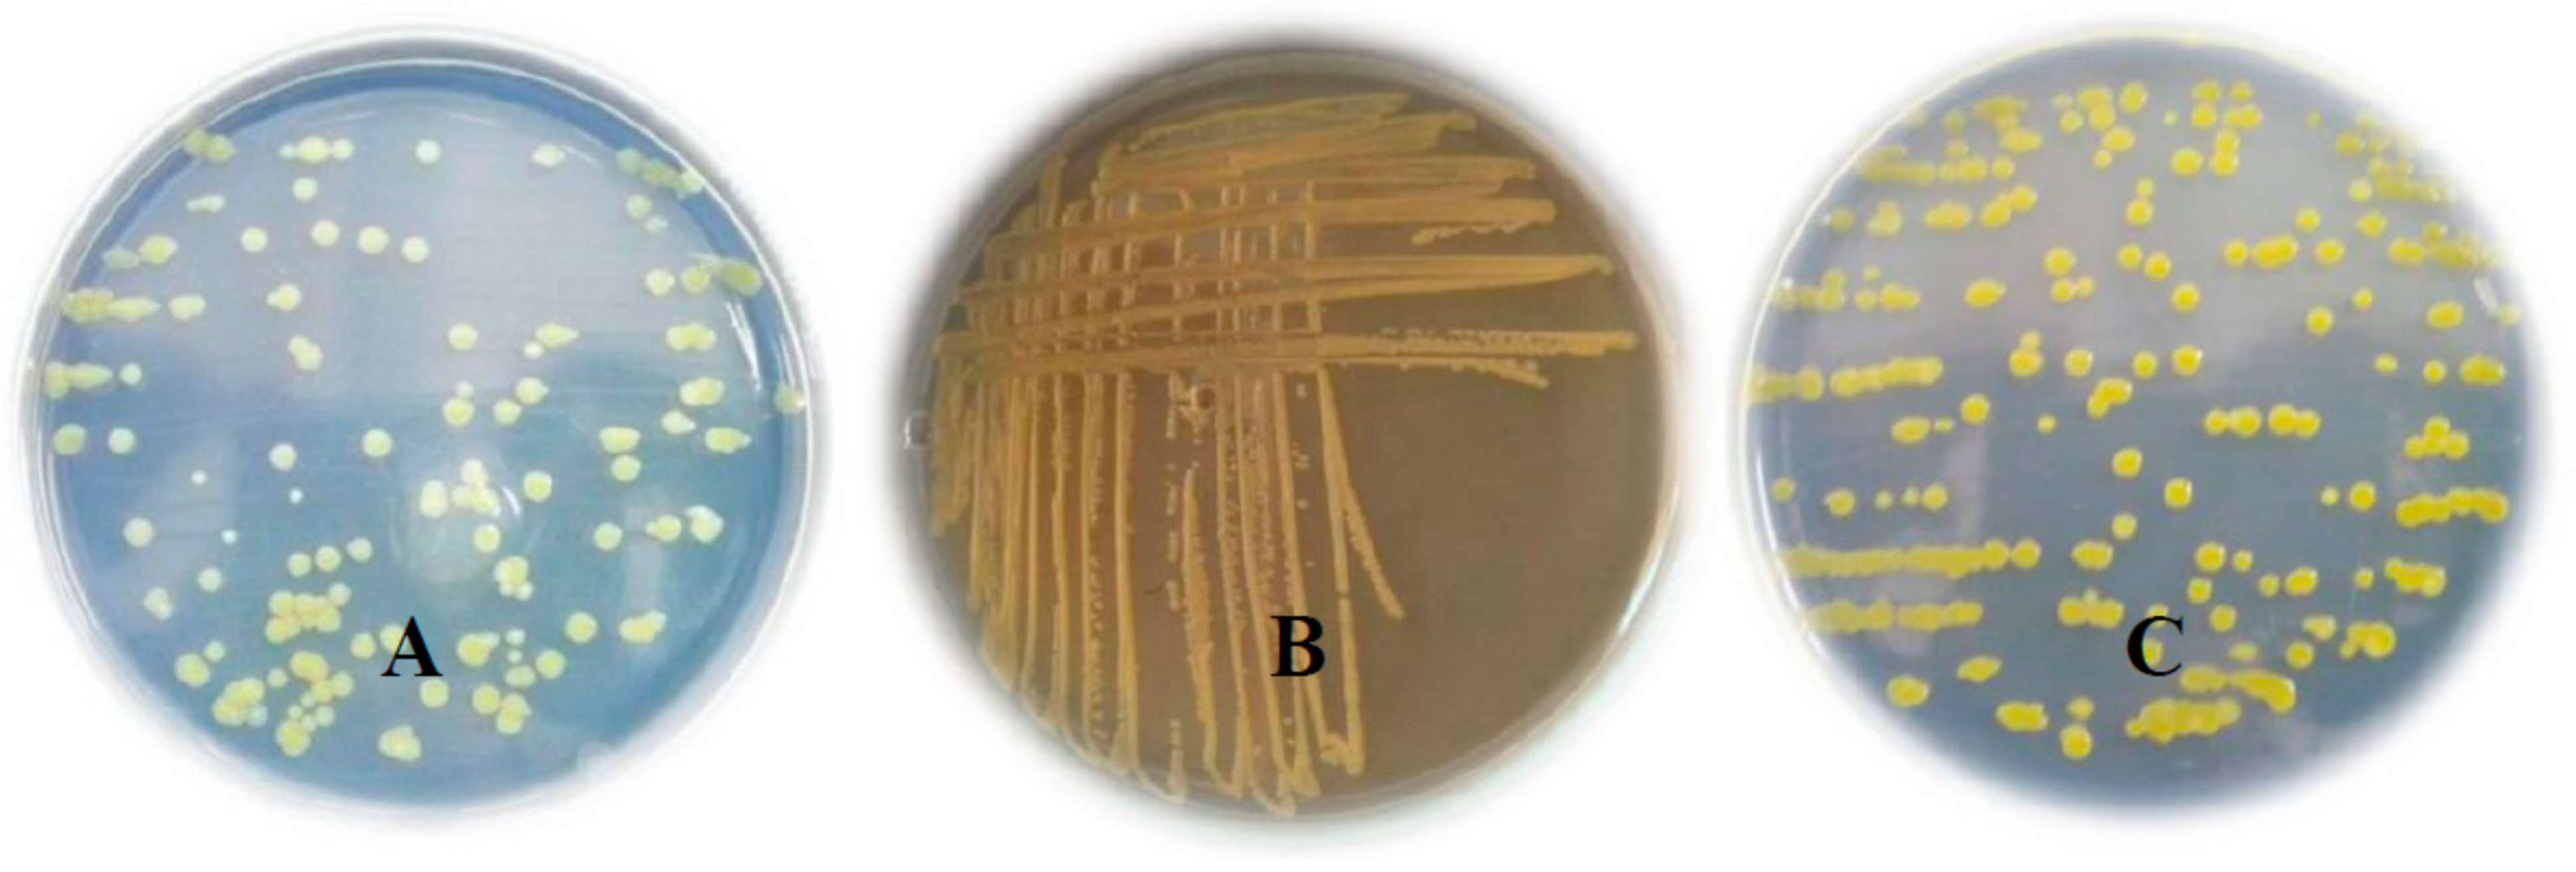

Suppression of Bacterial Leaf Spot by Green Synthesized Silica Nanoparticles and Antagonistic Yeast Improves Growth, Productivity and Quality of Sweet Pepper
Abstract
1. Introduction
2. Materials and Methods
2.1. Samples Collection and Isolation of the Associated Bacteria
2.2. Molecular Identification of Isolated Bacteria
2.3. Green Synthesis of Silica Nanoparticles (SiO2-NPs)
2.4. Experimental Design and Treatments
2.5. Measurements
2.5.1. Disease Incidence and Severity
2.5.2. Vegetative Growth Parameters
2.5.3. Polyphenol oxidase Activity Measurements
2.5.4. Leaf Chemical Composition
2.5.5. Fruit Yield and Quality
2.6. Statistical Analysis
3. Results
4. Discussion
5. Conclusions
Author Contributions
Funding
Institutional Review Board Statement
Informed Consent Statement
Data Availability Statement
Conflicts of Interest
References
- Abbasi, P.A.; Soltani, N.; Cuppels, D.A.; Lazarovits, G. Reduction of bacterial spot disease severity on tomato and pepper plants with foliar applications of ammonium lignosulfonate and potassium phosphate. Plant Dis. 2002, 86, 1232–1236. [Google Scholar] [CrossRef]
- Wai, K.P.; Siddique, M.I.; Mo, H.S.; Yoo, H.J.; Byeon, S.E.; Jegal, Y.; Mekuriaw, A.A.; Kim, B.S. Pathotypes of bacterial spot pathogen infecting Capsicum peppers in Korea. Pathol. J. 2015, 31, 428–432. [Google Scholar] [CrossRef][Green Version]
- Potnis, N.; Timilsina, S.; Strayer, A.; Shantharaj, D.; Barak, J.D.; Paret, M.L.; Vallad, G.E.; Jones, J.B. Bacterial spot of tomato and pepper: Diverse Xanthomonas species with a wide variety of virulence factors posing a worldwide challenge. Mol. Plant Pathol. 2015, 16, 907–920. [Google Scholar] [CrossRef]
- Ahmed, G.A. Evaluation the efficacy of some phenolic compounds in controlling bacterial spot disease and biochemical changes associated in pepper plants under greenhouse conditions. J. Plant. Prot. Pathol. 2016, 7, 655–662. [Google Scholar] [CrossRef]
- Abd-Alla, M.; Bashandy, S. Bacterial wilt and spot of tomato caused by Xanthomonas vesicatoria and Ralstonia solanacearum in Egypt. World J. Microbiol. Biotechnol. 2008, 24, 291–292. [Google Scholar] [CrossRef]
- Ashmawy, N.A.; Shoeib, A.A.; Youssef, H.F.B.; Mahmoud, S.M. Pathological, biochemical and molecular characterization of the seed-borne bacteria “Pantoea spp., Xanthomonas spp. and Pseudomonas spp.” from solanaceous plants in Egypt. J. Microbiol. Biotech. Food Sci. 2020, 10, 289–295. [Google Scholar] [CrossRef]
- Fraceto, L.F.; Grillo, R.; de Medeiros, G.A.; Scognamiglio, V.; Rea, G.; Bartolucci, R. Nanotechnology in agriculture: Which innovation potential does it have? Front. Environ. Sci. 2016, 4, 20. [Google Scholar] [CrossRef]
- Rajwade, J.M.; Chikte, R.G.; Paknikar, K.M. Nanomaterials: New weapons in a crusade against phytopathogens. Appl. Microbiol. Biotechnol. 2020, 104, 1437–1461. [Google Scholar] [CrossRef] [PubMed]
- Singh, A.; Singh, S.; Prasad, S.M. Silicon and nanotechnology role in agriculture and future perspectives. In Silicon in Plants: Advances and Future Prospects; Tripathi, D.K., Singh, V.P., Ahmed, P., Chauhan, D.K., Prasad, S.M., Eds.; CRC Press, Taylor&Francis Group: Boca Raton, FL, USA, 2017; pp. 101–116. [Google Scholar]
- Alvarado, M.A.; Guzmán, O.N.; Solís, N.M.; Vega-Baudrit, J. Recycling and Elimination of Wastes obtained from Agriculture by using Nanotechnology: Nanosensors. Int. J. Biosen. Bioelectron. 2017, 3, 00084. [Google Scholar] [CrossRef]
- Diacono, M.; Persiani, A.; Testani, E.; Montemurro, F.; Ciaccia, C. Recycling agricultural wastes and by-products in organic farming: Biofertilizer production, yield performance and carbon footprint analysis. Sustainability 2019, 11, 3824. [Google Scholar] [CrossRef]
- Arif, N.; Yadav, V.; Singh, S.; Singh, S.; Mishra, R.K.; Sharma, S.; Dubey, N.K.; Tripathi, D.K.; Chauhan, D.K. Current trends of engineered nanoparticles (ENPs) in sustainable agriculture: An overview. J. Environ. Anal. Toxicol. 2016, 6, 1–5. [Google Scholar] [CrossRef]
- O’Brien, P.A. Biological control of plant diseases. Australas. Plant Pathol. 2017, 46, 293–304. [Google Scholar] [CrossRef]
- Tsegaye, Z.; Assefa, F.; Tefera, G.; Alemu, T.; Gizaw, B.; Abatenh, E. Concept, principle and application of biological control and their role in sustainable plant diseases management strategies. Int. J. Res. Stud. Biosci. 2018, 6, 18–34. [Google Scholar]
- Freimoser, F.M.; Rueda-Mejia, M.P.; Tilocca, B.; Migheli, Q. Biocontrol yeasts: Mechanisms and applications. World J. Microbiol. Biotechnol. 2019, 35, 1–19. [Google Scholar] [CrossRef] [PubMed]
- Datnoff, L.E.; Rodrigues, F.Á.; Seebold, K.W. Silicon and plant disease. In Mineral Nutrition and Plant Disease; Datnoff, L.E., Elmer, W.H., Huber, D.M., Eds.; APS Press: St. Paul, MN, USA, 2007; pp. 233–246. [Google Scholar]
- Mostafa, D.M.; Awd Allah, S.F.A.; Awad-Allah, E.F.A. Potential of Pleurotus sajor-caju compost for controlling Meloidogyne incognita and improve nutritional status of tomato plants. J. Plant Sci. Phytopathol. 2019, 3, 118–127. [Google Scholar] [CrossRef]
- Wang, M.; Gao, L.; Dong, S.; Sun, Y.; Shen, Q.; Guo, S. Role of silicon on plant–pathogen interactions. Front. Plant Sci. 2017, 8, 701. [Google Scholar] [CrossRef] [PubMed]
- Gitaitis, R.D.; Chang, C.J.; Sijam, K.; Dowler, C.C. A differential medium for semiselective isolation of Xanthomonas campestris pv. vesicatoria and other cellulolytic xanthomonads from various natural sources. Plant Dis. 1991, 75, 1274–1278. [Google Scholar] [CrossRef]
- Hassan, E.O.; Zyton, M.A. Management of bacterial spot of pepper caused by Xanthomonas campestris pv. vesicatoria. Am. J. Biosci. Bioeng. 2017, 5, 41–49. [Google Scholar] [CrossRef]
- Ausubel, F.M.; Brent, R.; Kingston, R.E.; Moore, D.D.; Seidman, J.G.; Smith, J.A.; Struhl, K. Preparation of genomic DNA from bacteria. In Current Protocols in Molecular Biology; Ausubel, F.A., Brent, R.E., Kingston, D.D., Moore, J.G., Seidman, J.A., Eds.; Wiley: New York, NY, USA, 1995; pp. 630–634. [Google Scholar]
- Gomes, L.H.; Duarte, K.M.R.; Andrino, F.G.; Tavares, F.C.A. A simple method for DNA isolation from Xanthomonas spp. Sci. Agric. 2000, 57, 553–555. [Google Scholar] [CrossRef]
- Sambrook, J.; Fritsch, E.F.; Maniatis, T. Molecular Cloning: A Laboratory Manual, 2nd ed.; Cold Spring Harbor Laboratory, Cold Spring: Berlin/Heidelberg, Germany, 1989. [Google Scholar]
- Maniatis, T.; Fritsch, E.F.; Sambrook, J. Molecular Cloning: A Laboratory Manual; Cold Spring Harbor Laboratory Press: New York, NY, USA, 1982. [Google Scholar]
- Yuvakkumar, R.; Elango, V.; Rajendran, V.; Kannan, N. High-purity nano silica powder from rice husk using a simple chemical method. J. Exp. Nanosci. 2014, 9, 272–281. [Google Scholar] [CrossRef]
- Francesca, S.; Arena, C.; Mele, B.H.; Schettini, C.; Ambrosino, P.; Barone, A.; Rigano, M.M. The use of a plant-based biostimulant improves plant performances and fruit quality in tomato plants grown at elevated temperatures. Agronomy 2020, 10, 363. [Google Scholar] [CrossRef]
- Awad-Allah, E.F.A.; Attia, M.G.; Mahdy, A.M. Salinity stress alleviation by foliar bio-stimulant, proline and potassium nutrition promotes growth and yield quality of garlic plant. Open J. Soil Sci. 2020, 10, 443–458. [Google Scholar] [CrossRef]
- Le, K.D.; Kim, J.; Yu, N.H.; Kim, B.; Lee, C.W.; Kim, J.C. Biological control of tomato bacterial wilt, kimchi cabbage soft rot, and red pepper bacterial leaf spot using Paenibacillus elgii JCK-5075. Front. Plant Sci. 2020, 11, 775. [Google Scholar] [CrossRef] [PubMed]
- Mayer, A.M.; Harel, E.; Shaul, R.B. Assay of catechol oxidase: A critical comparison of methods. Phytochemistry 1965, 5, 783–789. [Google Scholar] [CrossRef]
- Jones, J.B., Jr. Laboratory Guide for Conducting Soil Tests and Plant Analysis; CRC Press: Boca Raton, FL, USA, 2001. [Google Scholar]
- Page, A.L.; Miller, R.H.; Keeney, D.R. Methods of Soil Analysis, 2nd ed.; Part 2: Chemical and microbiological properties, Agron, No. 9 (Part 2) in the Agronomy Series; ASA, SSSA, Inc.: Madison, WI, USA, 1982. [Google Scholar]
- Jackson, M.L. Soil Chemical Analysis; Prentice-Hall of India Pvt. Ltd.: New Delhi, India, 1967. [Google Scholar]
- Liang, Y.; Nikolic, M.; Bélanger, R.; Gong, H.; Song, A. Silicon in Agriculture: From Theory to Practice; Springer: Dordrecht, The Netherlands, 2015. [Google Scholar]
- Gomez, K.A.; Gomez, A.A. Statistical Procedures for Agricultural Research, 2nd ed.; A Wiley−Interscience Publication; John Wiley and Sons: New York, NY, USA, 1984. [Google Scholar]
- CoStat Software. Version 6.303; Microcomputer Program Analysis; CoHort Software: Monterey, CA, USA, 2004. [Google Scholar]
- Epstein, E.; Bloom, A.J. Mineral Nutrition of Plants: Principles and Perspectives, 2nd ed.; Sinauer Associates, Inc.: Sunderland, MA, USA, 2005. [Google Scholar]
- Siddiqui, H.; Ahmed, K.B.M.; Sami, F.; Hayat, S. Silicon Nanoparticles and Plants: Current Knowledge and Future Perspectives. In Sustainable Agriculture Reviews 41; Hayat, S., Pichtel, J., Faizan, M., Fariduddin, Q., Eds.; Springer: Cham, Switzerland, 2020; Volume 41. [Google Scholar] [CrossRef]
- El-Shetehy, M.; Moradi, A.; Maceroni, M.; Reinhardt, D.; Petri-Fink, A.; Rothen-Rutishauser, B.; Mauch, F.; Schwab, F. Silica nanoparticles enhance disease resistance in Arabidopsis plants. Nat. Nanotechnol. 2021, 16, 344–353. [Google Scholar] [CrossRef]
- Avestan, S.; Ghasemnezhad, M.; Esfahani, M.; Barker, A.V. Effects of nanosilicon dioxide on leaf anatomy, chlorophyll fluorescence, and mineral element composition of strawberry under salinity stress. J. Plant Nutr. 2021. [Google Scholar] [CrossRef]
- Xia, L.; Huang, H.; Feng, W.; Chen, Y. Silica nanoparticles boost plant resistance against pathogens. Sci. Bull. 2021, 66, 1151–1153. [Google Scholar] [CrossRef]
- Xi, Q.; Lai, W.; Cui, Y.; Wu, H.; Zhao, T. Effect of yeast extract on seedling growth promotion and soil improvement in afforestation in a semiarid chestnut soil area. Forests 2019, 10, 76. [Google Scholar] [CrossRef]
- Abou EL-Yazied, A.; Mady, M.A. Effect of boron and yeast extract foliar application on growth, pod setting and both green pod and seed yield of broad bean (Vicia faba L.). J. Appl. Sci. Res. 2012, 8, 1240–1251. [Google Scholar]
- Nassar, R.M.A.; Shanan, N.T.; Reda, F.M. Active yeast extract counteracts the harmful effects of salinity stress on the growth of leucaena plant. Sci. Hortic. 2016, 201, 61–67. [Google Scholar] [CrossRef]
- Vanitha, S.C.; Niranjana, S.R.; Umesha, S. Role of phenylalanine ammonia lyase and polyphenol oxidase in host resistance to bacterial wilt of tomato. J. Phytopathol. 2009, 157, 552–557. [Google Scholar] [CrossRef]
- Li, L.; Steffens, J.C. Overexpression of polyphenol oxidase in transgenic tomato plants results in enhanced bacterial disease resistance. Planta 2002, 215, 239–247. [Google Scholar] [CrossRef] [PubMed]
- Kavitha, R.; Umesha, S. Regulation of defense-related enzymes associated with bacterial spot resistance in tomato. Phytoparasitica 2008, 36, 144–159. [Google Scholar] [CrossRef]
- Taranto, F.; Pasqualone, A.; Mangini, G.; Tripodi, P.; Miazzi, M.M.; Pavan, S.; Montemurro, G. Polyphenol oxidases in crops: Biochemical, physiological and genetic aspects. Int. J. Mol. Sci. 2017, 18, 377. [Google Scholar] [CrossRef] [PubMed]
- Ngadze, E.; Icishahayo, D.; Coutinho, T.A.; Van Der Waals, J.E. Role of polyphenol oxidase, peroxidase, phenylalanine ammonia lyase, chlorogenic acid, and total soluble phenols in resistance of potatoes to soft rot. Plant. Dis. 2012, 96, 186–192. [Google Scholar] [CrossRef] [PubMed]
- Lobna, H.; Aymen, E.M.; Hajer, R.; Naima, M.B.; Najet, H.R. Biochemical and plant nutrient alterations induced by Meloidogyne javanica and Fusarium oxysporum f. sp. radicis lycopersici co-infection on tomato cultivars with differing level of resistance to M. javanica. Eur. J. Plant Pathol. 2017, 148, 463–472. [Google Scholar] [CrossRef]
- Ramzan, M.; Sana, S.; Javaid, N.; Shah, A.A.; Ejaz, S.; Malik, W.N.; Yasin, N.A.; Alamri, S.; Siddiqui, M.H.; Datta, R.; et al. Mitigation of bacterial spot disease induced biotic stress in Capsicum annuum L. cultivars via antioxidant enzymes and isoforms. Sci. Rep. 2021, 11, 9445. [Google Scholar] [CrossRef]
- Mathur, P.; Roy, S. Nanosilica facilitates silica uptake, growth and stress tolerance in plants. Plant Physiol. Biochem. 2020, 157, 114–127. [Google Scholar] [CrossRef]
- Pavlovic, J.; Kostic, L.; Bosnic, P.; Kirkby, E.A.; Nikolic, M. Interactions of silicon with essential and beneficial elements in plants. Front. Plant Sci. 2021, 12, 1224. [Google Scholar] [CrossRef]
- Song, A.; Xue, G.; Peiyuan Cui, P.; Fan, F.; Liu, H.; Yin, C.; Sun, W.; Liang, Y. The role of silicon in enhancing resistance to bacterial blight of hydroponic- and soil-cultured rice. Sci. Rep. 2016, 6, 24640. [Google Scholar] [CrossRef]

| Minerals (mg/g) | Amino Acids (mg/100 g) | Vitamins (mg/100 g) | |||
|---|---|---|---|---|---|
| K | 23.0 ± 0.05 ¶ | Arginine | 2.18 ± 0.07 | Vitamin B1 | 3.25 ± 0.03 |
| P | 16.0 ± 0.12 | Aspartic acid | 1.46 ± 0.12 | Vitamin B2 | 1.92 ± 0.10 |
| Ca | 0.84 ± 0.06 | Glutamic acid | 2.20 ± 0.24 | Vitamin B6 | 1.63 ± 0.23 |
| Mg | 1.78 ± 0.21 | Histidine | 2.89 ± 0.09 | Vitamin B12 | 0.55 ± 0.01 |
| S | 4.70 ± 0.13 | Isoleucine | 2.44 ± 0.13 | ||
| Fe | 0.07 ± 0.14 | Leucine | 3.15 ± 0.21 | ||
| Si | 0.12 ± 0.05 | Lysine | 2.99 ± 0.02 | ||
| Zn | 0.21 ± 0.10 | Methionine | 0.83 ± 0.14 | ||
| Mn | 0.05 ± 0.09 | Proline | 1.65 ± 0.10 | ||
| Cu | 8.90 ± 0.15 | Serine | 1.74 ± 0.13 | ||
| Mo | 0.55 ± 0.21 | Valine | 2.33 ± 0.11 | ||
| SiO2-NPs (ppm) | * Mean Bacterial Spot Severity | Mean | ||
|---|---|---|---|---|
| Antagonistic Yeast Extract (%) | ||||
| 0 | 3 | 5 | ||
| 0 | 5.06 a | 3.96 c | 3.58 d | 4.23 a |
| 50 | 4.46 b | 3.56 d | 2.32 f | 3.47 b |
| 100 | 2.98 e | 2.40 f | 1.64 i | 2.33 c |
| 150 | 2.06 g | 1.80 h | 1.20 j | 1.70 d |
| Mean | 3.68 a | 2.95 b | 2.18 c | |
| LSD0.05 | SiO2-NPs 0.082 | BCA 0.071 | Interaction 0.143 | |
| Treatments | Leaf Chemical Composition (%) of Sweet Pepper Plants | |||||||
|---|---|---|---|---|---|---|---|---|
| (BLS) Infection | BCA (%) | SiO2-NPs (ppm) | N | P | K | Ca | Mg | Si |
| Without | 0 | 0 | 3.00 o | 0.30 o | 2.45 n | 1.01 o | 0.28 n | 0.12 op |
| 50 | 3.40 mn | 0.37 kl | 3.00 k | 1.20 jk | 0.30 lm | 0.33 l | ||
| 100 | 4.10 h | 0.39 ij | 3.32 gh | 1.30 gh | 0.37 gh | 0.42 h | ||
| 150 | 4.60 d | 0.46 e | 3.71 e | 1.40 de | 0.44 d | 0.46 fg | ||
| 3 | 0 | 3.55 l | 0.35 m | 2.90 kl | 1.15 l | 0.33 j | 0.11 pg | |
| 50 | 3.95 i | 0.40 hi | 3.25 hij | 1.28 hi | 0.34 j | 0.40 ij | ||
| 100 | 4.30 f | 0.42 h | 3.60 f | 1.38 e | 0.42 e | 0.47 ef | ||
| 150 | 4.95 b | 0.52 b | 4.30 b | 1.44 c | 0.50 b | 0.53 c | ||
| 5 | 0 | 3.85 j | 0.41 h | 3.20 ij | 1.30 gh | 0.38 fg | 0.12 op | |
| 50 | 4.20 g | 0.43 g | 3.55 f | 1.34 f | 0.39 f | 0.45 g | ||
| 100 | 4.70 c | 0.50 c | 4.00 d | 1.47 b | 0.48 c | 0.51 d | ||
| 150 | 5.09 a | 0.55 a | 4.58 a | 1.54 a | 0.55 a | 0.60 a | ||
| With | 0 | 0 | 2.70 q | 0.21 q | 1.81 p | 0.85 q | 0.22 p | 0.10 q |
| 50 | 3.00 o | 0.30 o | 2.40 n | 1.00 o | 0.24 o | 0.26 n | ||
| 100 | 3.34 n | 0.35 m | 2.80 l | 1.13 lm | 0.31 kl | 0.34 l | ||
| 150 | 3.90 ij | 0.40 hi | 3.30 ghi | 1.26 i | 0.37 gh | 0.39 j | ||
| 3 | 0 | 2.90 p | 0.25 p | 2.28 o | 0.96 p | 0.28 n | 0.13 o | |
| 50 | 3.45 m | 0.32 n | 2.85 l | 1.08 n | 0.29 mn | 0.30 m | ||
| 100 | 3.56 l | 0.38 jk | 3.20 ij | 1.22 j | 0.36 hi | 0.41 hi | ||
| 150 | 4.21 g | 0.44 f | 3.95 d | 1.32 fg | 0.45 d | 0.48 e | ||
| 5 | 0 | 3.32 n | 0.36 lm | 2.65 m | 1.11 m | 0.32 jk | 0.10 q | |
| 50 | 3.75 k | 0.39 ij | 3.14 j | 1.18 k | 0.35 i | 0.37 k | ||
| 100 | 4.10 h | 0.45 ef | 3.38 g | 1.29 h | 0.39 f | 0.46 fg | ||
| 150 | 4.40 e | 0.48 d | 4.17 c | 1.41 d | 0.49 bc | 0.55 b | ||
Publisher’s Note: MDPI stays neutral with regard to jurisdictional claims in published maps and institutional affiliations. |
© 2021 by the authors. Licensee MDPI, Basel, Switzerland. This article is an open access article distributed under the terms and conditions of the Creative Commons Attribution (CC BY) license (https://creativecommons.org/licenses/by/4.0/).
Share and Cite
Awad-Allah, E.F.A.; Shams, A.H.M.; Helaly, A.A. Suppression of Bacterial Leaf Spot by Green Synthesized Silica Nanoparticles and Antagonistic Yeast Improves Growth, Productivity and Quality of Sweet Pepper. Plants 2021, 10, 1689. https://doi.org/10.3390/plants10081689
Awad-Allah EFA, Shams AHM, Helaly AA. Suppression of Bacterial Leaf Spot by Green Synthesized Silica Nanoparticles and Antagonistic Yeast Improves Growth, Productivity and Quality of Sweet Pepper. Plants. 2021; 10(8):1689. https://doi.org/10.3390/plants10081689
Chicago/Turabian StyleAwad-Allah, Eman F. A., Amany H. M. Shams, and Amira A. Helaly. 2021. "Suppression of Bacterial Leaf Spot by Green Synthesized Silica Nanoparticles and Antagonistic Yeast Improves Growth, Productivity and Quality of Sweet Pepper" Plants 10, no. 8: 1689. https://doi.org/10.3390/plants10081689
APA StyleAwad-Allah, E. F. A., Shams, A. H. M., & Helaly, A. A. (2021). Suppression of Bacterial Leaf Spot by Green Synthesized Silica Nanoparticles and Antagonistic Yeast Improves Growth, Productivity and Quality of Sweet Pepper. Plants, 10(8), 1689. https://doi.org/10.3390/plants10081689
